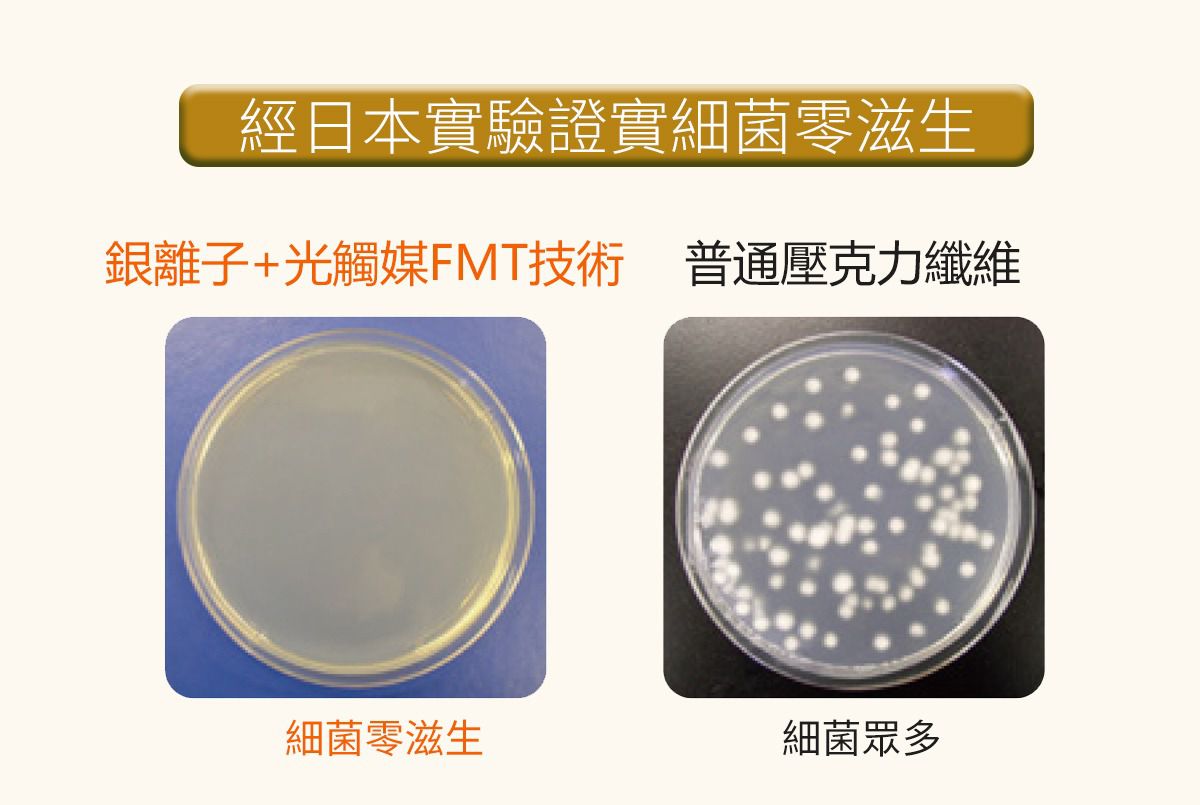
WIWI - 舒適休閒抑菌船型除臭襪-女-湛海藍

( 10000+ )
( 10000+ )
商品特色
獨家FMT清新分子技術,5秒解決腳臭
銀離子+光觸媒,滅650種細菌及病毒
100%從設計到車縫都是MIT
高圈數針織密度,緊密不變形

口碑嚴選

正品保證

加密付款

7天鑑賞
台灣天氣又濕又悶的,加上在外面奔波一天,回到家的雙腳很容易會有味道> <,今天編媽就要來推薦台灣製作的WIWI抗菌防臭襪子!從設計到車縫全部100%台灣製作,讓大家穿的安心,除臭襪使用天然清新分子技術來除臭,有效又健康,馬上來看看他們的介紹吧~

雙腳長期在悶濕的環境、黴菌細菌繁殖或者是穿著不易排汗的襪子,是造成雙腳有味道的三大主因,加上台灣海島型的濕熱天氣,真的是細菌的溫床!針對這3大主因,WIWI設計了業界第一的除臭襪~徹底幫大家解決掉臭味的問題

襪子除臭的原理是添加FMT光觸媒清新分子和加上網氣流透氣排汗的織法!抑制微生物滋生,達到抑菌的效果~

奈米級的銀離子Ag+能減少維持細菌生命的酶,從最根本的問題上控制細菌的繁殖,再透過光觸媒分解汗水的氣味,達到長效除臭!

看看實驗結果是不是很顯著👏🏻👏🏻
他們家送檢的結果也顯示消臭效果100分!!絕對是讓異味消失絕佳法寶

襪子不止除臭很厲害,織法上採用伸縮織法襪子彈性更佳,穿起來更舒適哦
/https://images.mamilove.com.tw/origin/setting/7285/7285-dd1ac17d82-1628661781.gif)
介紹完這麼強大的功能後,我們就來看看襪子的細節吧~襪子有很多款版型,而且大人、小孩全都有,媽咪們可以隨著需求來挑選哦

一拿到襪子馬上就摸了摸襪子的材質,手感很不錯,柔軟舒適!

近看襪子的細節們,採用不同密度的織法,透氣又不悶熱~

襪子還有通過檢測,吸水速乾狀況很不錯外,也不含有害的甲醛,穿得健康又安心

襪子最重要的彈性,表現也非常的優秀,穿起來不束縛
/https://images.mamilove.com.tw/origin/setting/7285/7285-a0432e2663-1628664032.gif)
翻開裡面看看布料,高圈數的針織密度,讓襪子綿密緊實,穿起來充滿包覆性,也不容易鬆脫變形哦!

一跟一般襪子的針數密度對比,就知道差異有多大了

襪子背面有做wiwi他們家的logo和尺寸的表示,這樣一眼就能看到襪子的尺寸,不用花時間找來找去的

襪口的設計也有做得比較緊密,不容易鬆掉

襪子設計簡單不浮誇,隨意搭配都OK

穿上後包覆性好,襪口的部分也不會太緊太勒,剛剛好有點緊度的貼在腳上,舒適度100分~

附上建議的洗滌方式,讓除臭襪壽命更長更耐穿


成人款尺寸表:


